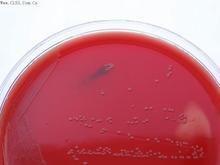
鉛黃腸球菌

基本信息
產品ID號:47133
產品編號:CL7099
中文名稱:鉛黃腸球菌 ATCC 700327
英文名稱:產品規格】5支/包裝
產品類別:質控菌株 >> Remel質控菌株
詳細信息
Culti-Loops 質控菌株接種環為5支/包裝,除彎曲菌屬需冷凍保存(-18℃)外,其它都應在2-8℃保存。
鉛黃腸球菌,腸球菌屬拉丁學名(Enterococcus Thiercelin and Jouhaud,1984) 細胞球形或卵圓形,0.6~2.0μm× 0.6~2.5μm,在液體培養基中呈成對或短鏈。不生芽孢。革蘭氏陽性。有時以鞭毛運動。沒有明顯的莢膜。兼性厭氧。化能異養,發酵代謝;可發酵的碳水化合物範圍廣泛,主要產L(+)-乳酸,但不產氣,最終pH4.2~4.6,營養需要複雜。接觸酶陰性。通常在10℃到45℃能生長(最適37℃),在pH9.6、6.5%NaCl中和40%膽鹽中也能生長。很少還原硝酸鹽。通常發酵乳糖。通常為Lancefield血清D群。廣泛出現於環境中,特別脊椎動物的糞便;有時引起化膿感染。 DNA的G+C為37~45mol%。 鉛黃腸球菌為人和動物胃腸道正常菌群之一屬腸球菌屬革蘭陽性球菌鏈球菌科的一群鉛黃腸球菌與糞腸球菌、屎腸球菌、鶉雞腸球菌等同屬腸球菌第二群帶組抗原在血瓊脂平皿上有不同的溶血作用能產生黃色色素有動力的一種腸球菌。可引起抵抗力低下宿主的多種機會感染。鉛黃腸球菌引起的感染在臨床上均有體溫升高、血象高、皮疹及相應感染灶部位的表現。臨床上不僅可引起尿路感染、皮膚軟組織感染還可引起危及生命的腹腔感染、敗血症、心內膜炎和腦膜炎等。鉛黃腸球菌引起的其他部位感染如心內膜、燒傷創面等我們的調查中未能發現。對例分離出鉛黃腸球菌的病例分析發現大部分感染者存在誘因常見誘因的有嚴重基礎疾病的老年人、對腸球菌無抗菌活性的廣譜抗生素如頭孢菌素的使用、腎功能不全、糖尿病、腫瘤、腎上腺皮質激素的套用、長期住院、重症監護室等。
模式種:
糞腸球菌(Enterococcus faecalis)。
鉛黃腸球菌 - 鉛黃腸球菌 ATCC 700327
D-麥芽糖/飴糖/麥芽糖/澱粉糖/4-O-α-D-吡喃葡糖基-D-葡萄糖/Maltose
D-綿子糖/棉子糖/密三糖五水/甜菜糖/蜜三糖五水/蜜里三糖/棉籽糖/桉糖/D-(+)-Raffinose pentahydrate
D-木糖/木糖/戊醛糖/木質醛糖/五碳醛糖/ D-戊醛糖/D(+)木質醛糖/D-Xylose
D-木酮糖/D(+)木酮糖/D-THREO-戊酮糖/D-Xylulose